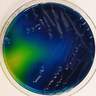
Sivasangari Shanmugam, profile picture

Principle and Uses of Microbiological instruments Transformation BY SIVASANGARI SHANMUGAM transmission Electron Microscopy (Tem) Scanning electron microscopy (sem) Phase contrast microscope Conjugation: Discovery, F+, F- and Hfr conjugation, F- genetic crosses Antibacterial chemicals bactericidal and bacteriostatic agents Polymers controlled delivery of therapeutic nucleic acid